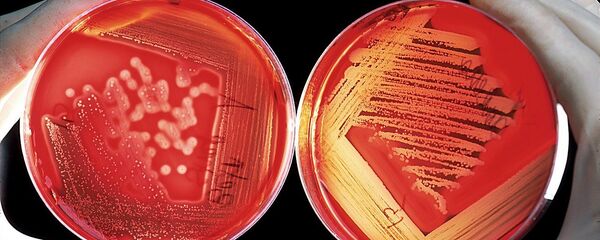
Крвне ћелије Крвне ћелије - Sputnik Србија

„Како човек одлучује шта да једе и колико? Чини се да је осећај ситости производ рада неколико ланаца неурона који управљају потрошњом различитих врста нутријената. Наше откриће и ово истраживање су ме натерали да потпуно другачије гледам на то како ради метаболизам“, изјавио је Метју Гилум са Универзитета у Копенхагену.
Хормон ФГФ21 је одавно познат биолозима. Раније су научници сматрали да јетра у току jела лучи ову супстанцу и помаже телу да несметано мења ниво инсулина, припремајући организам за прилив глукозе и других супстанци. Пре две године, Гилум и његове колеге, као и још једна група научника, истовремено су открили да је онемогућавање гена повезаног са производњом ФГФ21 доводило до крајње занимљивих последица у организмима мишева и мајмуна.
Животиње су, према речима Гилума, постајали праве сладокусце и јеле слатку храну практично непрекидно, чак и ако су одавно биле сите. Унос хормона у тело ових мишева доводило је до супротних последица — слатко их није интересовало.
У новом раду дански биолози су одлучили да провере да ли ФГФ21 игра сличну улогу у људском телу, у чијој се исхрани, за разлику од мишева, слаткиши редовно појављују, или је слична „способност“ јединствена карактеристика животиња. Да би то урадили, истраживачи су анализирали податке о исхрани скоро 6,5 хиљада волонтера који су учествовали у пројекту „Интер 99“ и сакупили узорке њихове ДНК за поређење структуре ФГФ21.
Испоставило се да ФГФ21 заиста контролише жељу за слаткишима и код људи. Истраживачи су успели да издвоје једну верзију тог гена, РС838133, а присуство његове две копије у ДНК је значајно повећавало вероватноћу да особа воли слаткише.
Своја открића научници су проверили током необичног експеримента. Они су позвали неколико „обичних“ људи и оних који воле слаткише да прођу једноставан тест „снаге воље“ — да поједу неколико кашичица шећера, а затим гладују наредних 12 сати. Током овог „гладовања“ научници су периодично узимали узорке крви и пљувачне узорке добровољаца, посматрајући промене у нивоу ФГФ21.
Научници истичу да је реакција на конзумирање шећера и код једних и код других била иста — ниво ФГФ21 у њиховој крви нагло је порастао реагујући на прилив калорија. С друге стране, концентрација ФГФ21 у крви особа које не воле слаткише била је знатно већа крајем експеримента него код љубитеља слатког. Такве разлике могу да се објасне јер ови други једу више шећера кад су већ сити него људи који не воле слаткише.
Занимљиво је да је присуство ове мутације у ФГФ21 повезано са два друга порока — жељом за алкохолом и дуваном. Истраживачи сматрају да се то објашњава чињеницом да ФГФ21 и са њим повезани хормони директно делују на центар за задовољство у мозгу човека и мењају његов рад. Како тај однос тачно функционише, Гилум и његове колеге планирају да сазнају у току даљих, ширих експеримената са волонтерима.